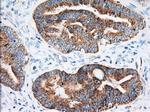
IGF2BP2 Antibody in Immunohistochemistry (Paraffin) (IHC (P))

Search
Invitrogen
IGF2BP2 Monoclonal Antibody (OTI3F9)
{{$productOrderCtrl.translations['antibody.pdp.commerceCard.promotion.promotions']}}
{{$productOrderCtrl.translations['antibody.pdp.commerceCard.promotion.viewpromo']}}
{{$productOrderCtrl.translations['antibody.pdp.commerceCard.promotion.promocode']}}: {{promo.promoCode}} {{promo.promoTitle}} {{promo.promoDescription}}. {{$productOrderCtrl.translations['antibody.pdp.commerceCard.promotion.learnmore']}}

Please note: We are reviewing Western blot images included in the antibody testing data in our catalog, including those provided by third parties. Unless expressly labeled or annotated as “raw-unedited”, Western blot images included in the antibody testing data in our catalog may have been edited, optimized or otherwise adjusted for presentation.
产品信息
MA5-25129
种属反应
宿主/亚型
分类
类型
克隆号
抗原
偶联物
形式
浓度
规格
纯化类型
保存液
内含物
保存条件
运输条件
RRID
靶标信息
IGF2BP2 is a member of the IGF-II mRNA-binding protein (IMP) family. It recruits target transcripts to cytoplasmic protein-RNA complexes. The protein contains several four KH domains and two RRM domains. It functions by binding to the 5' UTR of the insulin-like growth factor 2 (IGF2) mRNA and regulating IGF2 translation. Alternate transcriptional splice variants, encoding different isoforms, have been characterized. Autoantibodies against IGF2BP2 are detected in sera from some patients with hepatocellular carcinoma.
仅用于科研。不用于诊断过程。未经明确授权不得转售。
篇参考文献 (0)
生物信息学
蛋白别名: Hepatocellular carcinoma autoantigen p62; IGF-II mRNA-binding protein 2; IGF2 mRNA-binding protein 2; Insulin-like growth factor 2 mRNA-binding protein 2; p62; VICKZ family member 2
基因别名: IGF2BP2; IMP2; VICKZ2
Entrez Gene ID: (Dog) 478662




